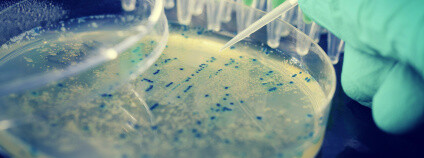

reklama
reklama
Názory a komentářePokud chcete v této rubrice zveřejnit svůj názor, pošlete nám ho na ekolist@ekolist.cz nebo využijte formulář Přidat názor. Vyhrazujeme si právo nezveřejnit názory vulgární, obsahující nepodložené urážky nebo nesrozumitelně formulované. Pokud výslovně neuvedete opak, předpokládáme, že souhlasíte se zveřejněním vašeho názoru v Ekolistu.cz. Všechny zde prezentované příspěvky vyjadřují názory jejich autorů, nikoli redakce Ekolistu.cz.
Libor Jankovský: Stanovisko Lesnické a dřevařské fakulty Mendelovy univerzity v Brně k otázce vývoje a vzniku Standardů ochrany přírody a krajiny14.7.2025
 Jako odborný garant vzniku Standardů péče o přírodu a krajinu (dále Standardy) a partner AOPK ČR cítíme v reakci na článek Jaroslav Kolařík: Katastrofa jménem Standardy péče o přírodu a krajinu, vydaný v Ekolistu dne 4. 7. 2025, potřebu vyjádřit následující. Jako odborný garant vzniku Standardů péče o přírodu a krajinu (dále Standardy) a partner AOPK ČR cítíme v reakci na článek Jaroslav Kolařík: Katastrofa jménem Standardy péče o přírodu a krajinu, vydaný v Ekolistu dne 4. 7. 2025, potřebu vyjádřit následující.
Jiří Michalisko: Hořící halda Heřmanice – kdo všechno to kryje?12.7.2025
 Největší ekologická škoda ve střední Evropě, na které i podle dohledatelných vyjádření státního podniku DIAMO hoří miliony tun hlušiny. Tisíce tun toxických látek, počínaje CO2, karcinogenními uhlovodíky a benzenem konče, to vše v době, kdy občané musely vyměnit pod hrozbou sankce každý jeden starý kotel na uhlí, protože škodí životnímu prostředí a jeho používání je nepřijatelné. Ve městě s více než 200 000 obyvateli, více než dvě desetiletí Hoří halda Heřmanice, kde jak se ukazuje zdaleka nebyly ukládány jen karbonské hlušiny z těžby uhlí. Všechno tohle probíhá v bezprostřední blízkosti lokality NATURA 2000, jen pár stovek metrů od mezinárodního toku řeky Odry. Největší ekologická škoda ve střední Evropě, na které i podle dohledatelných vyjádření státního podniku DIAMO hoří miliony tun hlušiny. Tisíce tun toxických látek, počínaje CO2, karcinogenními uhlovodíky a benzenem konče, to vše v době, kdy občané musely vyměnit pod hrozbou sankce každý jeden starý kotel na uhlí, protože škodí životnímu prostředí a jeho používání je nepřijatelné. Ve městě s více než 200 000 obyvateli, více než dvě desetiletí Hoří halda Heřmanice, kde jak se ukazuje zdaleka nebyly ukládány jen karbonské hlušiny z těžby uhlí. Všechno tohle probíhá v bezprostřední blízkosti lokality NATURA 2000, jen pár stovek metrů od mezinárodního toku řeky Odry.
Jan Palaščák: Co odhalil výpadek elektřiny v ČR11.7.2025
 Díky velmi dobré práci dispečerů a techniků ČEPS i provozovatelů distribučních soustav, ale také hasičů, policistů a dalších složek se po pátečním výpadku podařilo dodávky elektřiny v krátkém čase obnovit. Narozdíl od nedávné krizové situace na Iberském poloostrově se tedy nejednalo o úplný, respektive „katastrofální“ blackout, který by mimo jiné zahrnoval tzv. „start ze tmy.“ Situace byla časovým a územním rozsahem na hranici blackoutu („číslo 5 na škále 0-10“) a byla vyřešena kvalitně. Díky velmi dobré práci dispečerů a techniků ČEPS i provozovatelů distribučních soustav, ale také hasičů, policistů a dalších složek se po pátečním výpadku podařilo dodávky elektřiny v krátkém čase obnovit. Narozdíl od nedávné krizové situace na Iberském poloostrově se tedy nejednalo o úplný, respektive „katastrofální“ blackout, který by mimo jiné zahrnoval tzv. „start ze tmy.“ Situace byla časovým a územním rozsahem na hranici blackoutu („číslo 5 na škále 0-10“) a byla vyřešena kvalitně. Jakub Hruška: Vzkaz z Mauna Loa: CO₂ dál trhá rekordy10.7.2025
 V květnu byl na observatoři Mauna Loa na Havaji zaznamenán nový rekord v atmosférické koncentraci CO2, a to 427 ppm. Dlouhodobá změna koncentrace má na sobě vlny (viz graf), které jsou dané vegetační sezónou na severní polokouli – ta má mnohem více pevniny, a tedy i vegetace, a v květnu začíná plná vegetační sezóna, a proto od května do října atmosférická koncentrace CO2 klesá, protože je CO2 fotosynteticky spotřebováván vegetací (a tvoří se z něj pletiva rostlin, například dřevo, anebo salát, který jste včera měli k večeři). Od října do května zase CO2 stoupá, protože fotosyntetická fixace na severu ustane, a emisní zdroje (antropogenní i přírodní) mají možnost posunout koncentraci zase nahoru. V květnu byl na observatoři Mauna Loa na Havaji zaznamenán nový rekord v atmosférické koncentraci CO2, a to 427 ppm. Dlouhodobá změna koncentrace má na sobě vlny (viz graf), které jsou dané vegetační sezónou na severní polokouli – ta má mnohem více pevniny, a tedy i vegetace, a v květnu začíná plná vegetační sezóna, a proto od května do října atmosférická koncentrace CO2 klesá, protože je CO2 fotosynteticky spotřebováván vegetací (a tvoří se z něj pletiva rostlin, například dřevo, anebo salát, který jste včera měli k večeři). Od října do května zase CO2 stoupá, protože fotosyntetická fixace na severu ustane, a emisní zdroje (antropogenní i přírodní) mají možnost posunout koncentraci zase nahoru.
Petr Voráček: Zakazované mařiče zachraňovaly síť při blackoutu9.7.2025
 Česká přenosová soustava ČEPS, která řídí elektrizační soustavu, hromadně využívala při řešení blackoutu všechny dostupné mařiče. Výpadek linky číslo 411 a bloku Elektrárny Ledvice způsobil nedostatek elektřiny a aktivaci kladných služeb. Kladné služby dodávají například rychle startující diesely. V zápětí došlo vlivem výpadku spotřeby k převisu výroby elektřiny nad spotřebou a k aktivaci záporných služeb. Záporné služby poskytují klasické elektrárny snížením výroby a v posledních letech se prosazují velké elektrické kotle ohřivající vodu nebo páru pro vytápění. Tyto služby v objemu nižších desítek MW zatím poskytují i odsuzované a zakazované mařiče. Česká přenosová soustava ČEPS, která řídí elektrizační soustavu, hromadně využívala při řešení blackoutu všechny dostupné mařiče. Výpadek linky číslo 411 a bloku Elektrárny Ledvice způsobil nedostatek elektřiny a aktivaci kladných služeb. Kladné služby dodávají například rychle startující diesely. V zápětí došlo vlivem výpadku spotřeby k převisu výroby elektřiny nad spotřebou a k aktivaci záporných služeb. Záporné služby poskytují klasické elektrárny snížením výroby a v posledních letech se prosazují velké elektrické kotle ohřivající vodu nebo páru pro vytápění. Tyto služby v objemu nižších desítek MW zatím poskytují i odsuzované a zakazované mařiče.
Fakta o klimatu: Větrné a solární elektrárny se doplňují a obstojí i v českém počasí8.7.2025
 Fakta o klimatu zveřejnila detailní analýzu Jak spolehlivě vyrábí v Česku solární a větrné zdroje?, která ukazuje, jak spolehlivě dokážou v Česku vyrábět elektřinu větrné a solární elektrárny. Navzdory obavám z proměnlivosti obnovitelných zdrojů data ukazují, že při dobré kombinaci a doplnění záložními zdroji mohou OZE tvořit stabilní základ bezemisní energetiky. Fakta o klimatu zveřejnila detailní analýzu Jak spolehlivě vyrábí v Česku solární a větrné zdroje?, která ukazuje, jak spolehlivě dokážou v Česku vyrábět elektřinu větrné a solární elektrárny. Navzdory obavám z proměnlivosti obnovitelných zdrojů data ukazují, že při dobré kombinaci a doplnění záložními zdroji mohou OZE tvořit stabilní základ bezemisní energetiky.
Jaroslav Šebek: Za větším rozsahem protierozní ochrany v ČR stojí větší zornění a velká pole v erozních oblastech7.7.2025
 Podle plánů ministerstva zemědělství měla od začátku července tohoto roku platit nová
metodika k opatřením zajišťujícím dobrý zemědělský a environmentální stav půdy (DZES 5).
Zemědělští hospodáři mají v rámci tohoto opatření nově plně odpovídat za protierozní
ochranu půdy, ale mohou si sami do značné míry zvolit způsob této ochrany.
Podle plánů ministerstva zemědělství měla od začátku července tohoto roku platit nová
metodika k opatřením zajišťujícím dobrý zemědělský a environmentální stav půdy (DZES 5).
Zemědělští hospodáři mají v rámci tohoto opatření nově plně odpovídat za protierozní
ochranu půdy, ale mohou si sami do značné míry zvolit způsob této ochrany. Václav Skoblík: AI a energetika. Datacentra spotřebují do roku 2030 více elektřiny než Japonsko6.7.2025
 Mezinárodní agentura pro energii (IEA) zveřejnila nový výhled na dalších pět let a je to zajímavé čtení. Ve zprávě se mimo jiné dočteme, že datová centra budou do roku 2030 potřebovat dvakrát více energie než dnes. Globální spotřeba elektřiny datovými centry by měla do roku 2030 dosáhnout přibližně 945 terawatthodin (TWh), což je více než současná roční spotřeba v Japonsku. Hlavním pohonem růstu bude podle dokumentu umělá inteligence (AI). Mezinárodní agentura pro energii (IEA) zveřejnila nový výhled na dalších pět let a je to zajímavé čtení. Ve zprávě se mimo jiné dočteme, že datová centra budou do roku 2030 potřebovat dvakrát více energie než dnes. Globální spotřeba elektřiny datovými centry by měla do roku 2030 dosáhnout přibližně 945 terawatthodin (TWh), což je více než současná roční spotřeba v Japonsku. Hlavním pohonem růstu bude podle dokumentu umělá inteligence (AI). |
komentáře nejnovější nejčtenější Eliška Marie Nedvědová28.6.2026 Když aktivismus naráží na biologii: Odpověď na argumenty Svobody zvířat
reklama |
Ekolist.cz je vydáván občanským sdružením BEZK. ISSN 1802-9019. Za webhosting a publikační systém TOOLKIT děkujeme Ecn studiu. Navštivte Ecomonitor.
Copyright © BEZK. Copyright © ČTK, TASR. Všechna práva vyhrazena. Publikování nebo šíření obsahu je bez předchozího souhlasu držitele autorských práv zakázáno.
Copyright © BEZK. Copyright © ČTK, TASR. Všechna práva vyhrazena. Publikování nebo šíření obsahu je bez předchozího souhlasu držitele autorských práv zakázáno.